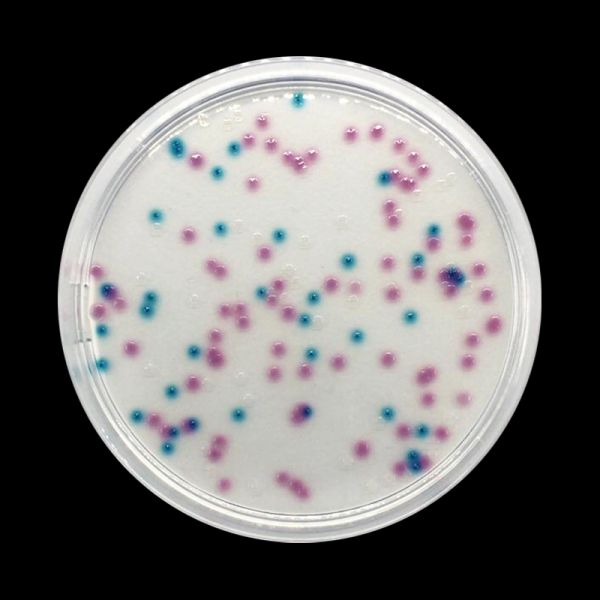

0.2 micron CP Select pipettes recommended for concentrating bacteria, whole cells, spores, pollen, and parasites from clear fluid
- Format: 10 Irradiated
- Code: GP4110
- Technologie: Consommables
- Application: Analyses microbiologiques
- Tags / Filtre: Kit pour Eau,Échantillonage,Virologie Alimentaire,Kit pour bouillons enrichis
CP Select fournit des facteurs de concentration inaccessibles aux technologies concurrentes, augmentant de manière exponentielle la possibilité de détecter la contamination à létat de traces et réduisant considérablement le temps et la main-duvre. Les fibres filtrantes creuses contenues dans les pipettes sont disponibles dans différentes tailles de pores qui sadaptent à différentes étendues analytiques (voir Le Guide de sélection). Grâce au procédé breveté délution de mousse humide dInnovaPrep, les agents biologiques filtrés par les pipettes sont récupérés et concentrés en quelques secondes dispersés dans quelques microlitres dun écouvillon compatible avec toute méthode de diagnostic. En fait, contrairement à la filtration à flux tangentiel, le processus de concentration dInnovaprep élimine les inhibiteurs solubles et les particules plus petites sont éliminées, ce qui évite les problèmes danalyse en aval.
- Format: 10 Irradiated
- Code: GP4110
- Technologie: Consommables
- Application: Analyses microbiologiques
- Tags / Filtre: Kit pour Eau,Échantillonage,Virologie Alimentaire,Kit pour bouillons enrichis